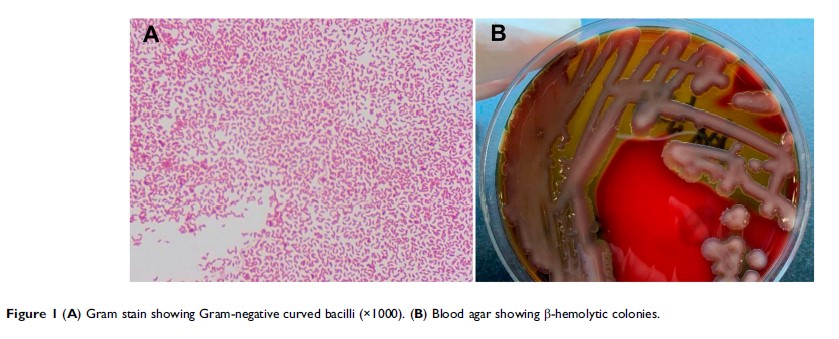

论文已发表
注册即可获取德孚的最新动态
IF 收录期刊
Case Report
非 O1/O139 群霍乱弧菌(NOVC)菌血症: 病例报告和文献回顾,2015–2019
Short Report
产 OXA-181 肺炎克雷伯菌在中国的首次报道

Clinical Trial Report
开放式腰椎后路手术中的双侧竖脊肌平面阻滞

Original Research
BDNF 与氯胺酮和丙泊酚的抗抑郁功效在电休克治疗中的作用:一项初步研究

Original Research
MsrA 通过抑制 NOX2-MAPKs/NF-κB 信号通路来遏制小胶质细胞的炎症活化和氧化应激,从而预防脱髓鞘病

Original Research
长非编码 RNA FEZF1-AS1 调节 CXCR4 促进骨肉瘤中的细胞增殖、Warburg 效应,并通过 miR-144 海绵化抑制细胞凋亡
